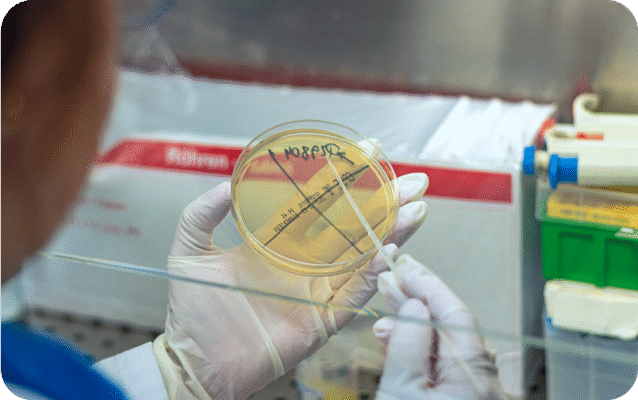
Rectangle 40 (6)

A prevenção é um dos pilares fundamentais da medicina moderna, e os testes laboratoriais desempenham um papel central neste processo. Muito antes de surgirem sintomas visíveis, muitas doenças podem ser detetadas através de análises clínicas simples e acessíveis, permitindo uma intervenção atempada e eficaz.
Os exames laboratoriais são, por isso, a primeira linha de defesa na proteção da saúde. Permitem monitorizar o funcionamento do organismo, identificar alterações precoces e avaliar fatores de risco. Desde análises de rotina, como hemogramas e testes de glicemia, até exames mais específicos, estes testes são essenciais para um diagnóstico precoce e para a adoção de medidas preventivas.
No Laboratório Manuel Pimenta, acreditamos que a prevenção começa com o conhecimento. Ao disponibilizar um serviço de análises fiável, rápido e acessível, contribuímos para que utentes e profissionais de saúde possam tomar decisões informadas e assertivas. Através de uma equipa experiente e tecnologia de última geração, garantimos resultados rigorosos que ajudam a manter a saúde sob controlo.
Investir na realização periódica de exames laboratoriais é investir na qualidade de vida. Com um simples gesto, é possível antecipar problemas, evitar complicações e adotar estilos de vida mais saudáveis. A saúde não deve ser apenas tratada — deve ser cuidada, acompanhada e, acima de tudo, prevenida.
No dia a dia, os testes laboratoriais tornam-se aliados discretos mas poderosos da medicina preventiva. E é com esse espírito que, no Laboratório Manuel Pimenta, continuamos a trabalhar para que cada resultado seja um passo em direção a uma vida mais longa, equilibrada e saudável.